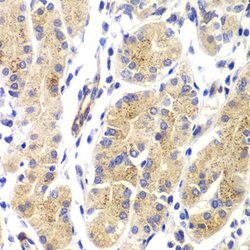
Invitrogen H-Ras Polyclonal Antibody 100 &mu;L | Buy Online | Invitrogen&trade; | Fisher Scientific

missing translation for 'onlineSavingsMsg'
Learn More
Learn More
Invitrogen™ H-Ras Polyclonal Antibody


Description
Purity is > 95% by SDS-PAGE.
Monomeric G protein Ras functions as a molecular switch linking receptor and nonreceptor tyrosine kinase activation to a number of downstream signaling pathways leading to distinct cytoplasmic or nuclear events. Each mammalian cell contains three Ras proto-oncogene coding for closely related Ras proteins: H-, K-, N-Ras. Oncogenic mutations in Ras genes are present in ~30% of all human cancers. Constitutive activation of Ras due to mutations or overexpression stimulates proliferation and inhibition of apoptosis. K-Ras mutations are common in pancreatic, colorectal and nonsmall-cell lung carcinomas; H-Ras mutations are common in bladder, kidney and thyroid carcinomas; N-Ras mutations are found in melanoma, hematological malignancies and hepatocellular carcinaoma.

Specifications
Specifications
| Antigen | H-Ras |
| Applications | Immunohistochemistry (Paraffin), Western Blot |
| Classification | Polyclonal |
| Concentration | 1 mg/mL |
| Conjugate | Unconjugated |
| Formulation | PBS with 50% glycerol and 0.02% sodium azide; pH 7.2 |
| Gene | HRAS |
| Gene Accession No. | P01112, P20171, Q61411 |
| Gene Alias | C-BAS/HAS; c-Ha-ras; c-Ha-ras p21 protein; c-Ha-ras transgene; C-HA-RAS1; c-has/bas p21 protein; c-H-ras; c-rasHa; c-ras-Ki-2 activated oncogene; CTLO; GTP- and GDP-binding peptide B; GTPase HRas; GTPase HRas, N-terminally processed; GTPase Hras1; HAMSV; Ha-ras; Ha-Ras1 proto-oncoprotein; Harvey ras1 protein; Harvey rat sarcoma viral (v-Ha-ras) oncogene homolog; Harvey rat sarcoma viral oncogene homolog; Harvey rat sarcoma viral oncoprotein; Harvey rat sarcoma virus oncogene; Harvey rat sarcoma virus oncogene 1; Harvey-ras; Hras; H-ras; H-ras 1 protein; HRas proto-oncogene, GTPase; HRAS1; H-Ras-1; Hras-1; H-RASIDX; Kras2; p19 H-RasIDX protein; p21ras; ras; Ras family small GTP binding protein H-Ras; ras p21; RASH1; transformation gene: oncogene HAMSV; transforming protein P21; v-Ha-ras Harvey rat sarcoma viral oncogene homolog |
| Gene Symbols | HRAS |
| Show More |
Product Title
By clicking Submit, you acknowledge that you may be contacted by Fisher Scientific in regards to the feedback you have provided in this form. We will not share your information for any other purposes. All contact information provided shall also be maintained in accordance with our Privacy Policy.
Spot an opportunity for improvement?